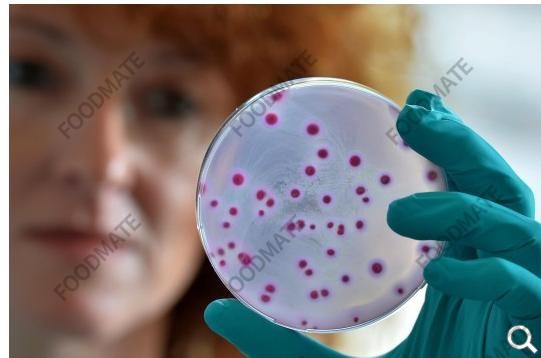

食品伙伴网讯 据德国媒体报道,德国萨克森-安哈尔特州2013年食品安全年度报告显示,该州食品抽检中十个样品中就有一个存在缺陷。除食品外,消保局还对化妆品及日用品进行抽检。
根据德国萨克森-安哈尔特州消保局周三在哈勒发布的该州2013年食品安全年度报告:该州食品抽检中十个样品中就有一个存在缺陷。或是错误的标注或是卫生问题。在2013年消保局共抽检食品11472件,样品含盖肉类,奶酪,乳品,及婴儿食品,其中1278个样品存在各种缺陷。其中530件存在标注问题,122件被评级为不能流通,124件存在卫生问题。
抽检目的在于向消费者提供安全的产品
被发现问题的样品数量能证明萨克森-安哈尔特州危机导向的消费者保护措施的有效性,该州社会部长Norbert Bischoff (SPD)表示。我们的目的在于向消费者提供安全的产品。“如果我们在抽检中没有发现问题,我就十分担忧了”,他表示。
萨克森-安哈尔特州消保局同样也抽检了1131件化妆品及其他产品,其中包括日用品及玩具。其中有14%的样品存在各种缺陷。
原文链接:http://www.welt.de/regionales/sachsen-anhalt/article132361206/Jede-zehnte-Lebensmittelprobe-hat-Maengel.html



地区:






